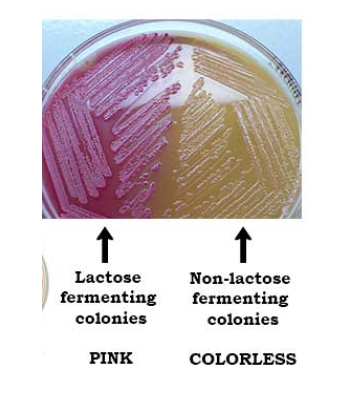
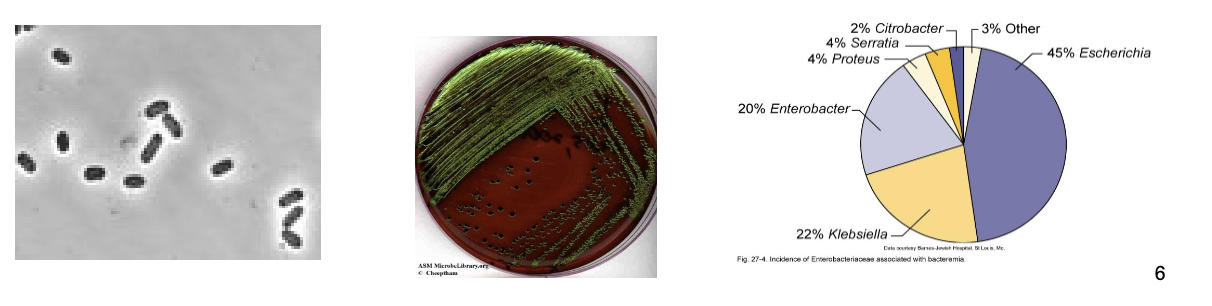
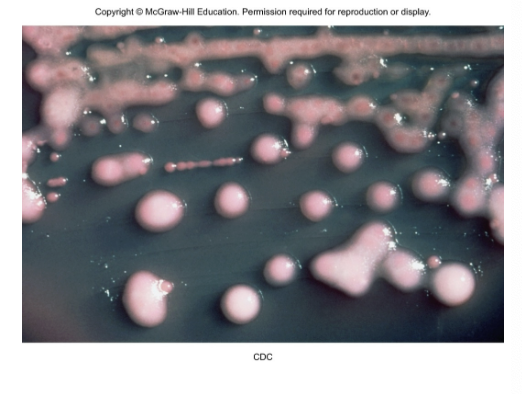
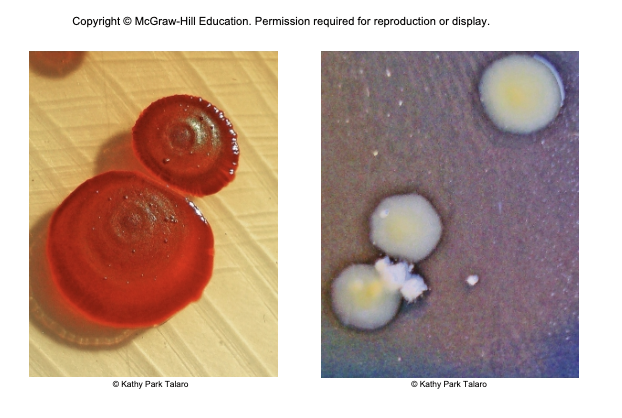
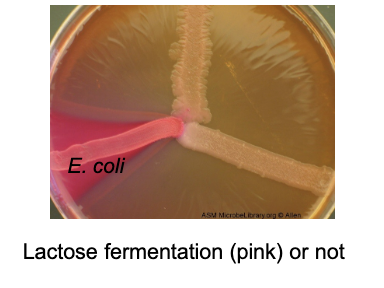

Family Enterobacteriaceae
enterics
large family of small, non-spore-forming gram-negative rods
enterobacterial common antigen (ECA)
many members inhabit soil, water, decaying matter, and are common occupants of large bowler of animals including humans
most frequent cause of diarrhea through enterotoxins
most diseases usually outside GI tract
enterics, along with pseudomonas sp., account for almost 50% of nosocomial infections

facultative anaerobes, grow best in air
all ferment glucose, reduce nitrates to nitrites, oxidase negative and catalase positive
divided into coliforms (lactose fermenters - E. coli, kelbsiella, enterobacter, cirtobacter, serratia) and non-coliforms (non-lactose fermenters- salmonella, shigella, yersinia)
enrichment, selective and differential media utilized for screening samples for pathogens
some have peritrichous flagella
Antigenic Structures and Virulence Factors
complex surface antigens contribute to pathogenicity and trigger immune response:
H - flagellar Ag
K - capsule and/or fimbrial Ag
type III secretion - like syringe insert into host cell
siderophores - iron binding
O - somatic or cell wall Ag - all have
endotoxin (LPS - heat stable)
exotoxins
serotype: O and H (e.g., E Coli O157:H7)


Escherichia Coli: the most prevalent enteric bacillus
most common aerobic and non-fastidious bacterium in gut
clinical disease: UTIs, neonatal meningitis, septicemia, gastroenteritis
150 strains; O antigen > 150; H antigen > 50
opportunistic infection - some have developed virulence through plasmid transfer, others are opportunists
Pathogenic Strains of E. coli: adhesion or toxin
enterotoxin E. coli (ETEC); 2 exotoxins (LTI, II< STA) causes severe diarrhea due to heat-lable (LTI, II) toxin and heat-stable toxin (STA) - stimulate secretion and fluid loss (traveler’s diarrhea); also has fimbriae
enteraggregative - EAEC - aggregrative adherence fimbriae, stacked brick appearance; stimulate mucus secretion - protect, toxins similar to ETEC
enteroinvasive E. coli (EIEC); rare-O123, O143, O164; (invasive plasmid antigen and hemolysin A) invade mucosa, lyse vacuole; causes inflammatory disease of the large intestine
enteropathogenic E. coli (EPEC): bind and destroy microvilli, intimin+ receptor- actin; linked to wasting form infantile diarrhea
enterohemorrhagic E. coli (EHEC), O157: H7 strain, shiga like toxin for eukaryotic ribosomes (STEC); AB toxin; toxin binds to intestinal villi and renal cells; bloody diarrhea; causes hemolytic uremic syndrome and kidney damage
Escherichia coli
pathogenic strains frequent agents of infantile diarrhea - greatest cause of mortality among babies
causes ~70% of traveler’s diarrhea
causes 50-80% UTI- adhesins and hemolysins important
neonatal meningitis- K1 especially; similar to neural cell adhesion molecule
coliform count - indicator of fecal contamination in water
large numbers, fast and easy to detect, fairly resistant
Opportunistic Coliforms
patients with cancer, diabetes, on steroids, COPD
klebsiella pneumoniae - normal inhabitant of nasopharynx, never on skin has large capsule
cause of nosocomial pneumonia, meningitis, bacteremia, wound infections, and UTIs (new superbug-Carbapenem resistant)
klebsiella granulomatis - genital granulomas,
subcutaneous nodule
may be an STI
3 weeks macrolides

enterobacter sp. - UTIs, surgical wounds, motile
citrobacter sp. - opportunistic UTIs and meningitis in neonates bacteremia
serratia marcescens - motile; produces a red pigment; causes UTIs, pneumonia, burn and wound infections, septicemia and meningitis
Noncoliform Lactose-Negative Enterics
proteus, moragnella, providencia-opportunists
salmonella and shigella - true pathogens
Opportunists: Proteus and Its Relatives
ordinarily harmless saprobes in soil, manure, sewage, polluted water, commensals of humans and animals
proteus sp. swarm on surface of moist agar in a concentric pattern and are involved in UTI, wound infections, pneumonia, septicemia, and infant diarrhea
resistant to many antibiotics
morganella morganii and providencia sp. involved in similar infections

Salmonella and Shigella
well-developed virulence factors, primary pathogens, not normal human flora
salmonelloses and shigelloses
some gastrointestinal involvement and diarrhea but often affect other systems
Typhoid Fever and Other Salmonelloses: Salmonella enterica
salmonella typhi - most serious pathogen of the genus; cause of typhoid fever; human host
S. cholerae-suis - zoonosis of swine
S. enteritidis - includes 1,700 different serotypes based on variation on O, H, and Vi
flagellated; survive outside the host
pathogenicity islands: type 3 secretion systems (injects invasion proteins); stimulate cAMP (watery diarrhea); inflammatory
resistant to chemicals - bile and dyes

Typhoid Fever
bacillus enters with ingestion of fecally contaminated food or water; occasionally spread by close personal contact
asymptomatic carriers; some chronic carriers shed bacilli from gallbladder
bacilli adhere to small intestine- invade through M cells, cause invasive diarrhea that leads to septicemia
ulceration, abscesses in liver, peritonitis
diagnosis- preliminary: hisory, symptoms, Abs, definitive requires culture
treat with chloramphenicol or sulfatrimethoprim
2 vaccines for temporary protection
live oral 4 doses, 2 weeks before travel, ,in. age 6, lasts 5 years
Ag injection - 1 dose, 2 weeks before travel, min. age 2, lasts 2 years

Animal Salmonelloses
salmonelloses other than typhoid fever are called enteric fevers (bacteremia), salmonella food posioning, and gastroenteritis
caused by one of many (>2500) serotypes of salmonella enterica; all zoonotic in origin but humans can become carriers
cattle, poultry, rodents, reptiles, animal, and dairy products
fomites contaminated with animal intestinal flora
usually less severe than typhoid fever but more prevalent
6-72 hours incubation, lasts 2-7 days
severe treat like typhoid fever
milder- supportive therapy
salmonella = most common food-borne cause of hospitalizations and deaths
Shigella and Bacillary Dysentery
shigellosis - incapacitating dysentery = lower abdominal cramping + bloody, mucoid, diarrhea, seizures under 2
four main types: S. dysenteriae, S. sonnei, S. flexneri, and S. boydii
species vary incidence/ severity, non-motile, no capsule (e.g. Shigella dysenteriae)
human parasites; ID: 50-200 bacterial cells
1-3 days incubation
replicate in small intestine: evade phagocytic killing; replicate in phagocytes, propel through cytoplasm to adjacent cells
shiga toxin (AB toxin) and exotoxin causes diarrhea
then invades villus of large intestine, does not perforate intestine or invade blood
enters peyer’s patches instigate inflammatory response; endotoxin and exotoxins
treatment- fluid replacement and ciprofloxacin and sulfatrimethoprim

Avoiding GI Infections
modes of transmission - thw 5 Fs (plus one W)
feces, fingers, flies, food, fomites, water (fluid?)
prevention
at home
sanitation, proper storage, and sufficient temperatures (refrigeration and cooking)
the 5 Bs while traveling (generally safe): bread, bananas, beer, bottled beverages, boiled water (no ice) [alternative B- bring your own]
CDC says boil it, cook it, peel it or forget it
The Enteric Yersinia Pathogens
Yersinia enterocolitica - domestic and wild animals, fish, fruits, vegetables, and water
bacteria enter small intestinal mucosa, some enter lymphatic and survive in phagocytes; inflammation of ileum; pain can mimic appendicitis
Y. pseudotuberculosis - infection similar to Y. enterocolitica, more lymph node inflammation
Nonenteric Yersinia pestis and Plague
nonenteric
tiny, gram-negative rod, unusual bipolar staining and capsules
virulence factors - capsular and envelope proteins protect against phagocytosis and allow intracellular growth
coagulase
endotoxin
murine toxin
vascular failure
type III secretion system
plasminogen activator protease- degrades C3b and C5a

Yersinia pestis
zoonotic
human develop plague through contact with wild animals (sylvatic plague) or domestic or semidomestic animals (urban plague) or infected humans
found in 200 species of mammals - rodents, without causing disease
flea vectors - bacteria replicates in gut, coagulase causes blood clotting that blocks the esophagus; flea becomes ravenous

Pathology of Plague
ID 3-50 bacilli
bubonic - bacillus multiplies in flea bite, enters lymph, causes necrosis and swelling called a bubo in lymph nodes
swollen tender nodes, fever, headache, weakness
septicemic - progression to massive bacterial growth; virulence factors cause intravascular coagulation subcutaneous hemorrhage and purpura - black plague
pneumonic - infection localized to lungs, highly contagious; fatal without treatment; pneumonia may be bloody

Diagnosis, Treatment and Prevention of Plague
diagnosis depends on history, symptoms, and lab findings from aspiration of buboes
treatment: streptomycin, tetracycline, or chloramphenicol
killed or attenuated vaccine available
prevention by quarantine and control of rodent population in human habitats